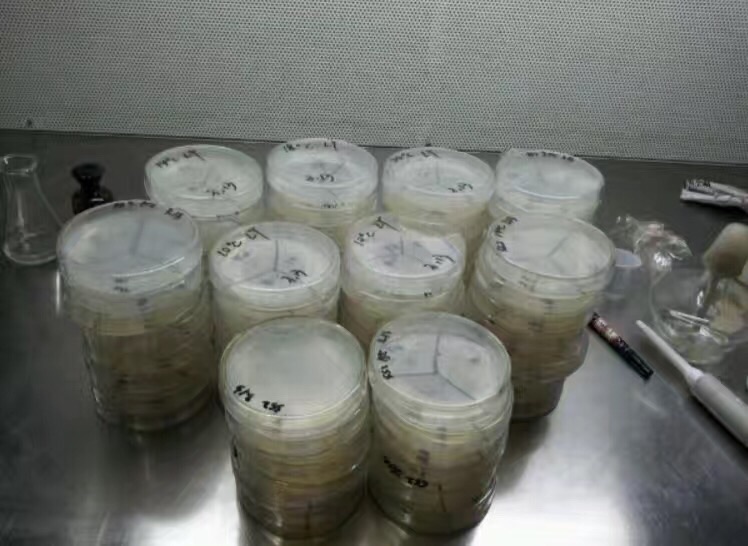

头图加载中...
从理工科实验女变成一个涛岛海贼潜水女教练
- 出发时间/2017-10-28
- 出行天数/59 天
- 人物/情侣/夫妻
曾经的我
曾经的我 ,一点不夸张的说,是个出门只认从家到学校的路怎么走,换条路都回丢的人。按照父母的教育理念,从小一路念到大学,再到研究生一路风平浪静。曾经我也以为就会和我的同学们一起,或者留校或者去各个实验室工作,我学的专业是植物分子生物学与基因工程(是不是听起来很高大上很像个科学家
),直到我和我老公的蜜月旅行(我俩是大学同学),一入潜水坑,再不想出来!
以前的我也是个白白静静的妹纸
入坑潜水
怎么入坑的潜水呢!请看我上篇游记
,总之考潜水证也是为了玩,能到各个美丽的潜点潜水。
加入海贼潜水
到海贼潜水来,是学潜水长以后的事了。在涛岛生活两个月,看起来很长,因为海贼,这个大家庭里所有的人,让我俩感觉2个月特别快,不想再离开,不想回到国内的城市继续尔虞我诈。又经过国内2个月的考虑,我和我老公(b哥)继续回来考教练,做潜水教练。
特别贴心的记得b哥的生日
开启IDC
决定的考教练,首先就是准备装备,以前出境,标配的一个一个旅行包,现在一人20公斤的行李额只能放下教材和装备。
背着我的padi小书包,心早就飞到了涛岛。
课程的十五天
陪读的大黄
Fay总监
大家在一起就是开心
理论上到怀疑人生
山哥的手艺,有会做饭的同学是多么幸福
IDC考试
最后的最后,成功